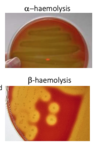

4.2 - 4.3 Bacterial growth, metabolism and taxonomy Flashcards








What physical properties are used to classify bacteria?
- Shape
- Staining
- Specialised features
What are the metabolic properties that are used to classify bacteria?
- Relationship with oxygen
- Biochemical activity
How is pathogenicity used to classify bacteria?
- Surface antigens
- Susceptibility to killing by specific viruses
- Capacity to cause disease
How is the genetic material in the bacteria arranged?
- Bacterial genomes are smaller than eukaryotes
- Bacteria don’t have a membrane bound nucleus
- The bacterial nucleoid comprises the genetic information (DNA) and the associated machinery (RNA, proteins) of the cell
- single chromosome is a closed circle of dsDNA, looped and supercoiled
- Variable in size
What are plasmids?
- Bacteria may also carry one or more plasmids
- Physically separate from chromosome and replicate independently
- Commonly occur as small circular, double stranded (supercoiled) DNA
- Variable size from 1 Kbp to several Mbp and copy number (1-40)
How much of bacterial DNA is functional genes?
- Majority of bacterial DNA encodes functional genes a bacterial strain
- Bacterial DNA does also contain pseudogenes and sRNAs, but no introns
- Bacterial lifestyle (free-living vs. pathogenic) tends to correlate with genome size
What is the difference between the core genome and pan genome?
- Core genome comprises the conserved genes of a species
- Pan genome is core genome and the accessory genome (variable content within a species)
What proportion does the core genome and the pan genome comprise?

Where do bacteria acquire genetic diversity from?
- Bacteria can evolve mia modification of existing genetic information (mutations)
- Bacteria can calso acquire genetic diversity via horizontal gene transer
- Mechanisms include plasmids
- Transposons (mobile sequence of DNA)
- Bacteriophages (virus that infects bacteria)
- Pathogenicity islands (series of genes that includes one or more virulence determinants)
- Integrons (genetic elements that allow efficient capture and expression of exogenous genes)
How were bacteria classified in the early days?
- Morphological, biochemical and metabolic classification defined prokaryotic taxonomic systems until the late 20th century
- Classification based on microorganism cell walls, cell shapes and the substances they consume

What is the common characteristic in prokaryotes used for phylogenetics?
- 16S ribosomal RNA (or 16S rRNA) is the component of the 30S small subunit of a prokaryotic ribosome
- 16S rRNA is highly conserved between different species of bacteria and archaea
- 16S rRNA gene can be used as a molecular clock for mapping evolution

What does 16s RNA do?
- It has structural roles where it acts as a scaffold defining positions of the ribosomal proteins
- Interacts with 23s rRNA aiding in the binding od the two ribosomal subunits
- 30S subunit binds to the Shine-Dalgarno sequence
- The 3’ of end 16S contains an anti-Shine-Dalgarno sequence
- The 3’-end of 16S RNA binds to the proteins S1 and S21 known to be involved in initiation of protein synthesis

How can 16S rRNA be used for phylogeny?
- Bacterial 16S rRNA gene contains highly conserved and hypervariable regions
- Nine hypervariable regions (V1-V9) of ~30-100 base pairs long
- Involved in the secondary structure of the 30S ribosomal subunit

How is the varibale regions of 16s rRNA used for taxonomy?
- Highly conserved sequences between V regions facilitates identification (via universal primers) by sequencing the same sections of the 16S sequence across different taxa
- 16S rRNA to measure relatedness: species-level >= 97%; genera >= 95%
What are the five bacterial shapes?

Is cell shape of bacteria fixed?
Cell shape is fixed due to the cell wall and peptidoglycan
What stain distinguishes cells by cell wall type?

How does gram staining separate bacteria into distinct groups?

How does gram staining work?
- Exploits differences in cell wall composition:
- Gram-positive bacteria have more peptidoglycan and retain the crystal violet stain
- Gram-negative bacteria have a less peptidoglycan and do not retain the crystal violet stain when washed and so are counter-stained by safranin.